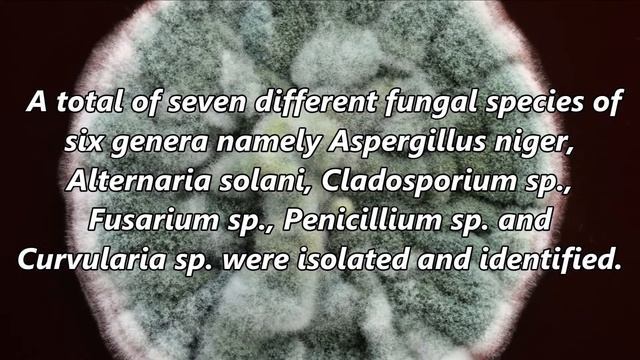
Incidence of Air-Borne Mycoflora of Baghsar Fort and its Allied Areas from Samahni Valley District смотреть онлайн

Автор / Канал: Грибы: зов природного богатства Страница 2

Бесплатный #ретрит для трех человек 🍄 #шаман #целитель #регрессия #гипноз #трип #мухомор #грибы

Hebras Colossal Fossil Side Quest Guide in Zelda Tears of the Kingdom

В Мариуполе зажгла огни главная ёлка города

Поход за грибами в Подмосковье ) эмоции зашкаливают )

EASY Chicken Casserole Meal! Shelf Stable Pantry Collaboration #foodstorage #budgetmeals

Отдых на природе: собираем грибы , ягоды 🫐

Не залишай, Iсусе не лишай

Ансамбль "Сяйво Украины"

Успешно земеделие - броят от 15. 03. 2022

Spice Diaries Anise

100% All Dark Ages Plants Real Life vs All Zombies - Plants vs Zombies Mod Real Life

Как я провел последний день лета...

осенний лес и его дары

Где находится гриб

A caccia di tartufi...

Вовк і семеро козенят українською

Ещё один газелист

Дидактична гра Четвертий зайвий

Belgium Chocolate Icecream | Chocolate Icecream | Quick and easy Chocolate Icecream
Incidence of Air-Borne Mycoflora of Baghsar Fort and its Allied Areas from Samahni Valley District

黑麴菌(Aspergillus niger)是屬於麴菌屬黑麴菌屬的黴菌。

Mushroom biriyani |How to cook mushroom biriyani |Agna vlog

16 декабря ингушет

秋天要多喝冬瓜三鮮湯,配料簡單,湯汁奶白,清淡不油膩,超好喝【阿朝哥美食 】#冬瓜三鮮湯 #三鮮湯 #chinesesoup
За каждым успешным каналом стоит личность, идея и сотни часов кропотливого труда. Если вы здесь, значит, автор «Грибы: зов природного богатства» уже сумел зацепить ваше внимание своим уникальным стилем или подачей. А мы на RUVIDEO позаботились о том, чтобы вы могли изучить весь архив его работ в максимально комфортных условиях — без лишней суеты и преград.
Почему за работами канала «Грибы: зов природного богатства» так интересно наблюдать? Всё просто: это честный контент, который находит отклик в сердцах зрителей. На нашем ресурсе вы можете смотреть онлайн все видео любимого автора бесплатно и в хорошем качестве. Нам важно, чтобы вы видели каждую деталь и слышали каждый нюанс, поэтому мы используем только стабильные плееры из открытых источников Rutube.
Следите за новинками канала, пересматривайте старые шедевры и открывайте для себя новые грани творчества «Грибы: зов природного богатства». Мы постоянно обновляем ленту, чтобы у вас под рукой всегда были самые свежие выпуски. Никаких сложных регистраций — только вы и творчество, которое вдохновляет. Приятного вам путешествия по миру авторского контента на RUVIDEO!
Видео взято из открытых источников Rutube. Если вы правообладатель, обратитесь к первоисточнику.